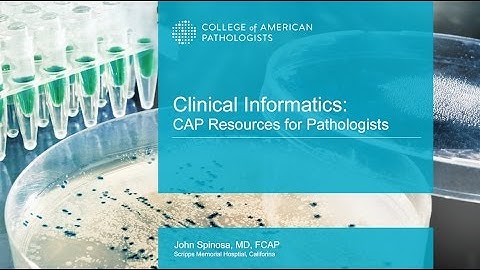
Clinical Informatics: CAP Resources for Pathologists

⬇ DOWNLOAD NOW
Kalau muncul iklan pop-up, tutup lalu klik tombol kembali
Download lagu Informatics for the Pathologist secara gratis hanya untuk keperluan promosi. Dukung artis favorit kamu dengan membeli musik original di iTunes atau platform resmi lainnya.
 Pathology Informatics: Overview
Pathology Informatics: Overview
Clinical Informatics: CAP Resources for Pathologists
Clinical Informatics: CAP Resources for Pathologists
 What is Informatics? with Dr. Mark Tuthill on Digital Pathology Today Episode 7
What is Informatics? with Dr. Mark Tuthill on Digital Pathology Today Episode 7
 The University of Pathology Informatics
The University of Pathology Informatics
 Practical Pathology Informatics Demystifying informatics for the practicing anatomic pathologist
Practical Pathology Informatics Demystifying informatics for the practicing anatomic pathologist
 Informatics and Laboratory Medicine: Dr. David McClintock
Informatics and Laboratory Medicine: Dr. David McClintock
 Q&A with Peter Ouillette, Digital Pathology Operations Manager
Q&A with Peter Ouillette, Digital Pathology Operations Manager
 Glenn Edwards on pathology informatics and the importance of decision support tools
Glenn Edwards on pathology informatics and the importance of decision support tools